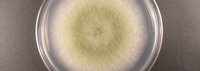

味噌、清酒、醤油用種麹の違い
久しぶりの投稿になりました。さて、先回は「黄麹菌」の中に、味噌用、清酒用、醤油用と目的に応じた菌がありますよ、と言う話をしました。
さて、では、目的別にはどのように切り分けしているのでしょうか?それは、麹菌が生産する酵素の違いによって、「こういう酵素を出すなら味噌に向いている」「こういう酵素なら清酒用だな」と分類しています。
もちろん、実際には、酵素の生産の仕方だけでなく、原料との相性や、麹の生育の仕方などの観点もありますが、今日は酵素だけに絞ってお話しします。
「麹菌には生産しない酵素はない」という人もいるぐらい、麹菌は数百種類、あるいは数千種類の酵素を生産すると考えられています。
全容はまだ解明されていません。ただ、麹としての特性を理解するために、ざっくりと2つの代表的な酵素を取り上げて説明したいと思います。
アミラーゼとプロテアーゼ
一つがアミラーゼというこうそ、もう一つがプロテアーゼという酵素です。酵素は専用ノコギリという話も以前にしたと思いますが、アミラーゼはデンプンという大きな物質をチョキチョキと切り刻んで、糖という小さな物質に変えていく役目を果たします。
イメージとしてはレゴブロック。レゴが何個も並んでいるのがデンプンで、ブロックの一個一個が糖と思ってください。そして、レゴとレゴを切り離すのに専用ノコギリの酵素がないと外せない。
この、アミラーゼ、人間の唾液(つば)にも入っています。お米を噛むと甘くなりますよね。それは人間のつばにもアミラーゼが入っていて、デンプンを糖に変えるから味を感じることができるわけです。(詳細は専門家に譲りますが、人間は小さな物質じゃないと体内に取り込めません。糖が舌を通じて体内にはいっていくときに、甘味として味を感じます。)
そして、もう一つプロテアーゼ。プロテインって聞いたことありますよね?たんぱく質を英語で言うとプロテインです。デンプンを糖に変えるのがアミラーゼとしたら、このたんぱく質という大きな物質をアミノ酸という小さな物質に切り刻む酵素がプロテアーゼです。(アミノ酸ってよくきくとおもいますが、アミノ酸がたくさん繋がるとたんぱく質になるんですね。)
このアミノ酸は、人間の味覚としては「旨味」として認識されます。お肉やお魚、そして、大豆などの「旨味」のもとですね。ちなみに、「アミノ酸」というのは物質の総称で、たんぱく質をつくるアミノ酸は20種類ぐらいあります。たとえば、旨味の素として知られる「グルタミン酸」は「アミノ酸」の仲間です。
ここも話がややこしくなりがちですが、「アジア人」の中に「日本人」も「中国人」も「インドネシア人」も「ミャンマー人」も「アフガニスタン人」もいると思ってください。「アジア人」だから「日本人」じゃないってことにはならないですよね?同様に「アミノ酸」の中に「グルタミン酸」があるわけです。
生物学は「***酸」がやたら多いですが、一つ一つ守備範囲を確かめていきましょう。「地球人」「アジア人」「日本人」「関西人」「京都人」と全部「***人」みたいなもので、どの程度の範囲の言葉なのか、どの「***酸」は、どの「***酸」の上位のカテゴリの言葉なのか、整理していくと、色んなことが分りやすくなります。面倒な人は「***酸」と一口に言っても守備範囲が違うんだと思ってください。
閑話休題。整理すると、注目すべき酵素はアミラーゼとプロテアーゼ、それぞれ、デンプンを糖にし「甘味」、たんぱく質をアミノ酸にし「旨味」に関わる。これがポイントになります。
味噌、醤油、清酒の違い
さて、ここまで来れば、ピンと来る人はピンとくると思います。味噌、醤油、清酒、それぞれ、味を思い出してください。
味噌は甘さも旨味もありますよね?味噌の甘さというのが違和感のある人は東日本や東海地方の方でしょうか?西京味噌とか麹の甘味をかなり感じます。
味噌に対して醤油は、甘味がほとんどありません(九州の人怒らないで!分ってます。その話は後日します。)。そして清酒、清酒では「旨味」は、「雑味」として敬遠される傾向。そして「糖」はアルコールを造るために必須の物となっています。
そう、おわかりですね、甘味も旨味もそれなりに欲しい味噌は「アミラーゼ」や「プロテアーゼ」を両方ともそれなりに出す麹菌、醤油は「プロテアーゼ」に特化したタイプ、逆に清酒用は「アミラーゼ」に特化したタイプとなります。
あとは、この派生形。八丁味噌のように「大豆です!旨味です!」と言う味噌には、味噌用の菌の中でもよりプロテアーゼの強いもの、清酒でも、「旨味」を求める濃厚な酒質を造りたい時などには、そこそこ「プロテアーゼ」が強い物を酒蔵さんに提供するときがあります。(もちろん、他にも色んな観点があります)
この段落の最初の表は、その関係を表した物です。
あま酒で麹の違いを楽しんでみよう
さて、味噌、醤油、清酒でそれぞれ酵素の出方が違うということは、当然「甘味」「旨味」のバランスも違う。ということは、「麹」そのものの味も違うと言うことになります。
この「麹」の味の違いが直接出るのが、麹をそのまま食べることになる甘酒や塩麹。特に、塩や砂糖を加えていない甘酒はモロに麹の違いが出ます。
味噌メーカーさんの麹やあま酒は、清酒メーカー酸に比べると、やはり「旨味」も載っているし、甘味もしっかりしているものが多いように思います。一方、清酒メーカーさんのあま酒は、糖の甘味によるすっきりとしたシンプルな味わいのあま酒になっていることが多いようです。
甘味に着目すると、醸造メーカーさんでないお菓子メーカーさんなどのあま酒だと、麹から甘味を持ってこず、砂糖などで甘味をつけているケースもあり、比較的分りやすい甘味になっていたりします。
また、香りについては、味噌メーカーさんの菌で「アミラーゼ」「プロテアーゼ」両方ともそこそこ強いことは、結局、他の酵素や生成物も多くなりがちなので、麹独特の香り(栗香といいます)も強めになる傾向です。
全体としては、味噌メーカーさんのあま酒は、甘味、旨味、香りなどが、よりはっきりとしており、清酒メーカーさんのあま酒は、それらがより軽やかというところでしょうか。
是非、色んな種類のあま酒を楽しんで、麹の違いに思いをはせていただけたらなあとおもいます。
今日の話はここまで。
いいなと思ったら応援しよう!
最後までご覧いただきありがとうございました。
私のプロフィールについては、詳しくはこちらをご覧ください。
https://note.com/ymurai_koji/n/nc5a926632683